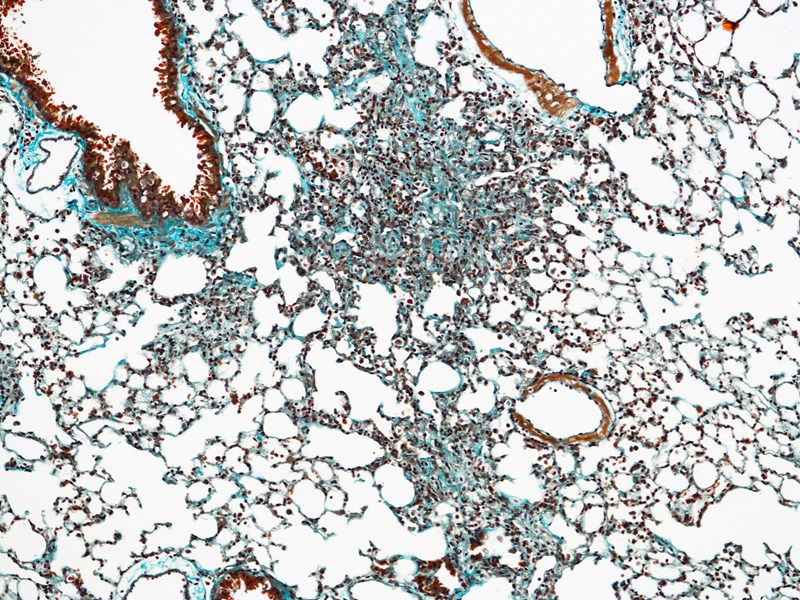

Human Organs

Liver Disease
In excess of 1 million people die annually as a consequence of liver cirrhosis which is the end-stage of fibrotic liver disease.
Cirrhosis results from progressive fibrosis caused by over 100 different types of liver diseases affecting all age groups and ethnicities.
Metabolic Dysfunction-Associated Steatotic Liver Disease (MASLD which results from obesity and/or type II diabetes is alone estimated to affect 30% of the globe population (2.5 Billion people).
At present, there are no clinically approved medicines that directly halt or reverse the fibrotic process that leads to cirrhosis.
Lung Disease
Lung fibrosis is caused by more than 100 different types of lung disease and affects millions of people worldwide.
Idiopathic pulmonary fibrosis (IPF) is a specific and aggressive form of lung disease that has no cure and a similar life expectancy as lung cancer (20% survival over 5-years).
Two recently approved anti-fibrotic drugs for IPF, pirfenidone and nintedanib, can slow down the progressive loss of patient’s lung function.
Novel and more effective medicines are urgently needed for IPF.

Kidney Disease
Chronic kidney disease (CKD) affects at least 70 million people worldwide, with risk factors including ageing, diabetes and high blood pressure.
The common pathway of CKD to renal failure is the progressive formation of fibrotic scar tissue which causes structural damage to functional components of the kidney.
There are no cures for CKD other than transplantation.
The only clinically approved CKD treatments are blood pressure drugs (ACE inhibitors and angiotensin receptor blockers) which slow down, but do not stop disease progression.